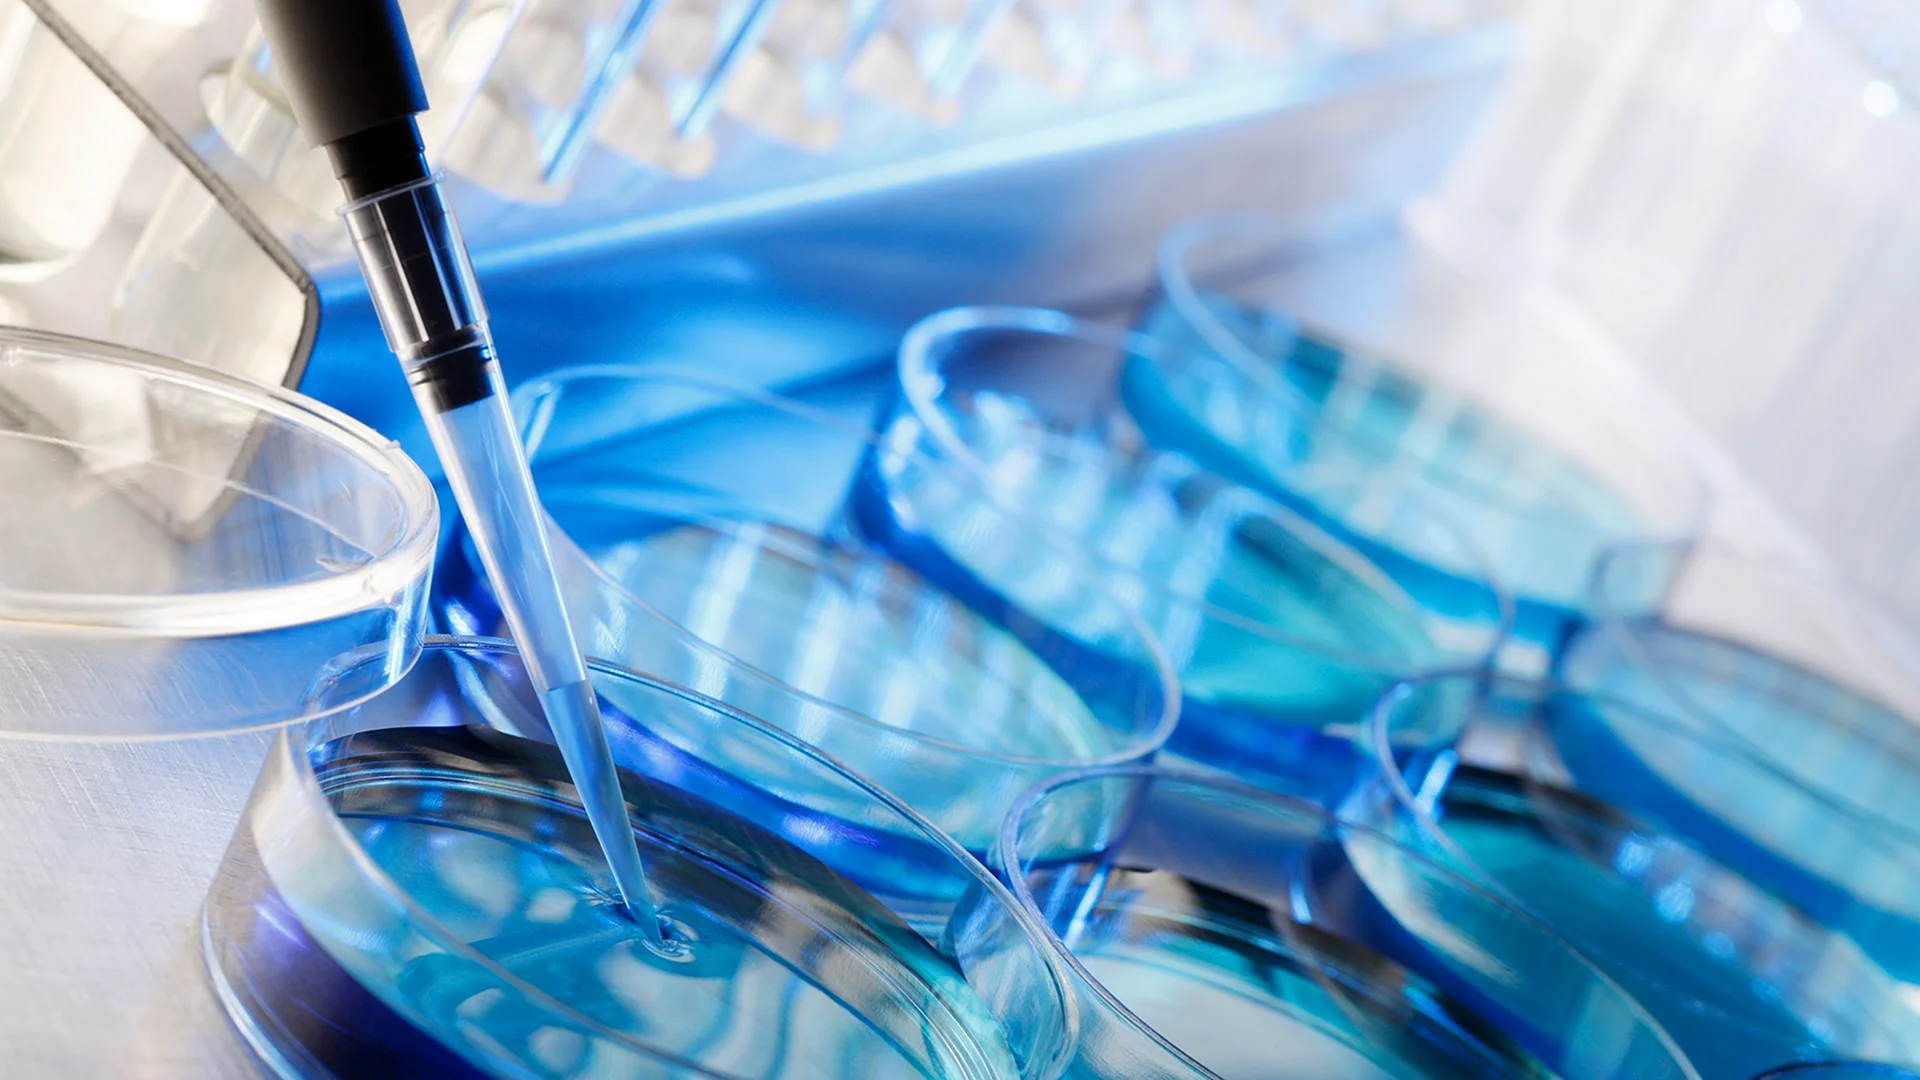

Познакомьтесь с нашей захватывающей галереей фотографий, полной удивительных изображений микробов. Вы найдете здесь более 50 фотографий и картинок, которые вас удивят и заинтригуют. Загляните в мир микробиологии и увидьте скрытые миры, которые обычно остаются незамеченными. Не упустите эту возможность посмотреть захватывающие фотографии и расширить свои знания в этой удивительной области науки. Приготовьтесь быть пораженными и вдохновленными этой невероятной коллекцией фотографий. Приглашаем вас приступить к просмотру!

Оцените картинки







